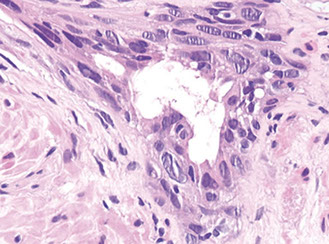

Prostate
Prostate anatomy and histology
Clinical correlation
Tissue sampling and processing
Biomarkers for the detection and management of prostate carcinoma
Inflammatory conditions
Diagnosis of Limited Adenocarcinoma (AC) of the Prostate
Mimickers of AC of the Prostate
Reporting Cancer
Grading Prostate AC
Finding Atypical Glands Suspicious for Cancer
Prostatic Duct AC
Neuroendocrine Differentiation in Benign and Malignant Prostate
Muncinous differentiation in Benign and Malignant Prostate
Benign and Malignant Prostate Post Treatment
Urothelial Carcinoma
Mesenchymal tumors and tumor-like conditions
Misc Benign and Malignant Lesions
Prostatic Urethral Lesions
Markers for Detection and Treatment of Prostatic Ca
Anatomy and Histology
Anatomy
30-40 g in adult without BPH
- base proximal at bladder neck and apex distal at urogenital diaphragm
- prostatic urethra runs centrally c 35 degree anterior bend
- posterior surface has thin filmy layer of CT known as Denonvilliers fascia that separates the seminal vesicles and prostate from the rectum
- divided into inner and outer zones, which differ histologically and by prevalence of disease
-- the inner zone predominantly affected by BPH, and the outer zone gets carcinoma (though not 100% of the time of course)
Verumontanum or seminal colliculus is a protrusion found on the posterior wall of the prostatic urethra and is the point where the urticle and ejaculatory ducts merge c the prostatic urethra
Can also divide into 4 zones:
1. Central zone
- cone-shaped c apex at verumontanum and base at the bladder neck
2. Anterior fibromuscular stroma
- 1/3 of the prostate has few glands and consists of sm muscle and dense fibrous tissue
3. Preprostatic region (periurethral ducts and transition zone)
- transition zone most affected by hyperplasia
4. Peripheral zone
- distal to central zone and has horseshoe-shaped structure
Histology
Consists of epithelial and stromal cells
- epithelial cells arranged in glands consisting of ducts that branch out from urethra and end in acini
-- ducts are long tubular structures c branching, and acini are more rounded structures grouped into lobular units
Epithelial cells of the prostate are urotheliall (transitional) cells, secretory cells, basal cells and neuroendocrine cells
- proximal portions of prostatic ducts are lined by urothelium similar to urethra, and distal portions of the ducts and some acini can have alternating areas of cuboidal and columnar epithelim mixed c urothelium
- if urothelium seen in more distal ducts, known as urothelial metaplasia (may be a misnomer)
Columnar secretory cells are tall c pale to clear cytoplasm
- (+) PSA, PSAP
- neg HMWK
- corpora amylacea (round laminated hyaline eosinophilic or calcified structures) in 25% of glands in men 20-40 yo, and are rare in carcinomas
- lipofuscin can be seen as red-orange or purple inclusions in columnar cells, and can also be seen in seminal vesicle cells
Basal cells are underneath the secretory cells
- cigar-shaped or resemble fibroblasts and oriented parallel to BM
- can be difficult to find in b9 glands and may be hard to differentiate from fibroblasts
- basal cells are absent in adenocarcinoma of the prostate and can be found in conditions that mimic prostate cancer
-- basal cells have more ovoid nuclei c lighter chromatin (similar to sm muscle cells), whereas fibroblasts have more pointed nuclei and are more hyperchromatic
- basal cells can have prominent nucleoli, resembling high grade PIN
(+) HMWK, tho can occasionally be neg in normal glands
- negative PSA, PSAP, SMA, S100
Cells c neuroendocrine differentiation
Stromal cells
Includes sm sk muscle cells, fibroblasts, nerves and endothelial cells
- sk muscle from urogenital diaphragm extends into prostate at apex
- small nerve bundles and occasionally ganglion cells and paraganglia can occasionally be seen in prostate
- Cowper glands can occasionally be seen on needle bx
a) Central zone, b) Anterior fibromuscular stroma, c) transition zone, d) peripheral zone, e) periurethral gland,

seminal vesicle (posterior)
Benign prostate c corpora amylacea

Benign Prostatic Hyperplasia (BPH)
aka nodular hyperplasia, MC urologic dz in men
- can be lateral, middle lobe or posterior enlargement
-- middle lobe enlargement occurs at bladder neck
-- posterior lobe hyperplasia includes enlargement of the median bar, on the posterior aspect of urethra
The smallest nodules are have loose mesenchyme and prominent small round vessels
- some nodules can be made of only sm muscle, and may be called a leiomyoma of the prostate if it is a large symptomatic mass of sm muscle
The largest and most numerous hyperplastic nodules almost always laterally situated and occur in periurethral zone near proximal end of verumontanum
- glandular part made of small and large acini, some c papillary infoldings and projections c central fibrovascualr core (not a specific finding)
- stroma has sm muscle and fibrous tissue, which can sometimes have pallisading nuclei mimicking a neural tumor
- often lymphocytic or plasma cell infiltrates around glands
Should not dx hyperplasia on core needle specimens
- transition zone not sampled in many occasions
- histologic findings (except c stromal nodules) do not correlate c size of prostate or obstructive sx
- may falsely reassure clinician that he sampled the lesion of concern
- should instead dx as "benign prostatic tissue", not BPH
BPH

Clinical correlation
Digital rectal exam (DRE)
Think cancer if prostate asymmetrical, indurated, or has hard nodules on DRE
- the more irregular the prostate on DRE, the higher the positive predictive value (PPV) of a prostate bx
-- abnormal DRE has PPV of ~25%, and DRE also has low sensitivity;
~1/2 of lower stage (T1C) in peripheral zone (expect them to be palpable, and ~1/4 in transition zone (anterior) and not expected to be palpable
- poor reproducibility amongst urologists as to abnormal DRE
Transrectal Ultrasound (TRUS)
Most prostate cancers appear hypoechoic relative to the normal peripheral zone (can be hyper- or isoechoic); but TRUS has poor sens and spec
- TRUS mostly used to direct bx
- endorectal MRI and multiparametric MRI (mpMRI) seem to have modest sens and spec, under investigation, may be better at detecting higher-grade cancer and reduces over-detection of low-grade ca
- PET modalities also being investigated
Prostate-Specific Antigen (PSA)
Synth'd in the ductal epithelium and prostatic acini, found in b9, hypertrophic and malig conditions
- normally secreted into prostatic ducts and becomes part of the seminal fluid
- seminal fluid normally has gel-forming proteins that trap spermatozoa at ejaculation; PSA liquefies this clot to free the sperm (is a serine protease)
Total PSA
Prostate ca pts normally have inc PSA relative to normal men
- if PSA levels 0-2 risk of cancer <1%, 2.5-4 ng/mL risk of ca ~18% c normal DRE, if 4-10 ng/mL, risk of ca if DRE normal is ~25%; if >10 ng/mL raises to 67%
- prostatitis, infarct, instrumentation of prostate, and ejaculation inc serum PSA
- should wait 4-6 wks after inciting event to measure PSA for clinical use
- Finasteride (to tx BPH and hair loss) dec PSA by 1/2
PSA Density
Amt of PSA produced per gram of prostate tissue
- calculate by dividing total serum PSA by est gland vol (usually determined by TRUS, tho not very accurate)
- upper normal val of 0.15
- not very sure if helpful
Age-Specific PSA reference ranges
Raising the upper limit of normal in older men has the effect of bx'ing younger pts c low PSA levels and doing less bx's in older men c higher levels
PSA Velocity (Rate of change of PSA)
Higher rate of change (>0.75 ng/mL per year) had higher rates of prostate cancer, only 1/20 pts without prostate ca had high PSA velocities
- requires >=3 PSA measurements over period of 1-2 yrs b/c of substantial short-term variability
Molecular forms of PSA
Once in serum, PSA bound to serine protease inhibitors (either a1-antichymotrpsin [ACT], a-2 macroglobulin or a-1 protein inhibitor)
- PSA bound to ACT is the most immunoreactive and the only clinically useful form to dx prostate ca
- a minority of PSA (5-40%) is free (noncomplexed) PSA
- total PSA Is both free and complexed PSA
- the % of free PSA correlates to risk of prostate cancer; high free PSA levels assoc c lower risk of ca
- free PSA levels of <10% worrisome for ca
- estimating % free PSA done in men c normal DRE and serum PSA bwt 4-10 ng/mL to decide to bx after an initially normal biopsy
- complexed PSA can be directly measures, but not usually done
PSA relation to Post-therapy Follow-up Bx's
PSA levels should be undetectable after radical prostatectomy; if PSA is detected (>0.2 ng/mL) think recurrent or persistent dz
- radiotherapy drops PSA to a nadir; if PSA inc >2 ng/mL after nadir, indicates tx failure
PLCO trial found nearly identical mortality rates from prostate ca mortality in pts screened c PSA and DRE
- the European Randomized Study of Screening for Prostate Cancer found similar results
- American Urological Assoc (AUA) decided shared decision making for men aged 55-69 yo but recommended against screening in younger pts at below avg risk


ISUP modified 2014
Biomarkers for the detection and management of prostate carcinoma
Emerging prognostic factors
clinicopathologic stage, Gleason grade and serum PSA routinely used to guide tx
- numerous molecular markers have been indicated in the development of prostate ca
Epigenetic Changes in Prostate Cancer
Changes in DNA methylation marks, along c epigenetic gene silencing, the earliest somatic genome changes in prostate cancer
- assay strategies to detect specific DNA sequences c 5-meC is promising
- hypermethylation of glutathione S-transferase-pi (GSTP1) transcriptional regulatory sequences has been consistently detected in >90% of prostate ca
-- GSTP1 encodes an enzyme responsible for detoxifying electrophiles and oxidants, shielding them from gene damage
-- loss of GSTP1 expression is an early event in carcinogenesis, and can also be seen in proliferative inflammatory atypia (PIA) and >70% HG-PIN
Two waves of epigenetic alterations in prostate cancer have been suggested, some assoc c early and some with later stages of ca development
ERG-ETS Gene Fusions
a study in 2005 found >1/2 prostate ca's had rearrangement of the androgen-responsive promoter elements of TMPRSS2 gene to one of the 3 members of the ETS transcription factors family
- helped to better understand prostate molecular diagnosis, though may not may not be useful prognostic marker
- ERG is now available as an IHC, and ERG overexpression is correlated with ERG fusion status
PI3k / mTOR pathway
Has role in cell growth, prolif and prostate ca oncogenesis
- PTEN is a negative regulator of this pathway; so loss of PTEN tumor suppressor correlates c mTOR pathway activation and is assoc c poor px
Other tumor suppressors and oncogenes
p53 expression and Gleason score on bx may be indicators of relapse after prostatectomy
- this has been shown in more recent genome-wide studies
- p27 (a cell cycle inhibitor) also has been assoc c px after prostatectomy
- Bcl2 and myc oncogenes may be useful as prognostic adjuncts to histology
- must be wary of potential variability in performance of new markers
Integrated genomics
3 subclasses of prostate tumors based on distinct patterns of gene expression using cDNA microarrays were found
- 2 of 3 classes were assoc c high-grade and advanced stage tumor and tumors assoc c recurrence
-- MUC1 was found in aggressive subgroups
-- AZGP1 was highly expressed in favorable subgroups
Array-based comparative genomic hybridization (array CGH) has also been able to distinguish bwt 3 prognostic groups in prostate ca
1. del 5q21 and 6q15 del assoc c better outcomes
2. 8p21 (NKX3-1) and 21q22 (causing TMPRSS2-ERG fusion) del group and an 8q24 (MYC) gain with loss of 10q23 (PTEN) groups assoc c mets and aggressive tumors
Tumors c "stemlike" signatures and p53 and PTEN inactivation assoc c very poor outcomes
- TMPRSS2-ERG fusion had intermediate outcome

Molecular alterations in oncogenesis and progression of prostate cancer
PCA TISSUE BASED GENOMIC TESTS
(LASOP 2021)
Decipher Prostate Cancer Test
- Erho et al. PLoS One 2013; Karnes et al.
J Urol 2013; Klein et al. Eur Urol 2014;
- Knudsen et al. J Mol Diagn 2016
WHAT is the test?
• Ribonucleic acid based genomic classifier (GC) test using 22 RNAs from coding/non protein coding regions derived from FFPE RP specimens or Bx
WHO is the test for?
• Patients with adverse pathology at RP or Bx
WHY do the test?
• Predict risk of early metastatic (within 5 years) disease and PCA specific mortality following RP
• GC 0 1 (increments of 0.1=10% increase metastatic risk)
• Select patients who may benefit from multimodal
therapy/clinical trial
Clinical Endpoint: Metastasis
Tissue sampling and Processing
Needle biopsy technique
Sextant biopsies ample parasagittal midlobe region of prostate (even tho most prostate ca's arise posterolaterally)
- transitional zone bx may be helpful if original bx neg but there is still high suspicion for ca, or for active surveillance (helps reduce risk of undersampling)
- biopsies should be taken from the posterolateral region
- 3 levels should be made from each prostate biopsy paraffin block
- different biopsy sites should be submitted in different containers, which facilitates going back to tack more bx's in care of "atypical / suspicious" dx, in which case there is usually cancer in surrounding area
MRI-Targeted Biopsy (NEJM 2018)
Conclusions: 12% increase in clinically significant & 13% decrease in clinically insignificant PCA
Clinically significant PCA: GS 3+4=7
Ø pattern 4 quantitation
TURP sampling
Initially can put in 8-10 caps random tissue
- if pt younger than 65 yo, may be best to submit all tissue to find all stage T1a lesions
- if a T1a is found on initial sampling, may be best to submit the remaining tissue (up to 16 caps max)
Inflammatory conditions
Acute and Chronic Prostatic Inflammation
Although common in practice, rarely seen in bx as are tx'd c abx
- acute bacterial prostatitis shows neuts in and around acini, intraductal desquamated cellular debris, stromal edema
-- focal nonspecific acute inflam more freq seen
Prostatic abscesses MC in pts c preexisting bladder outlet obstruction 2/2 lower UTI, usually 2/2 coliform organisms, and rarely from dissemination from extraurinary source of infx (MC is strep infx of skin)
- may arise 2/2 instrumentation as complication of bx
Symptomatic chronic prostatitis can't be distinguished histologically from the chronic inflam seen in specimens removed for BPH
- usually periglandular plasma cell infiltrates
- best to dx "chronic inflam" vs "chronic prostatitis"
Clinically, prostatitis can elevate PSA
- acute and chronic inflam can also mimic carcinoma
Malakoplakia
As in bladder, most men c prostatic malakoplakia usually have UTI, MC is E coli
- can mimic ca, resulting in induration and hypoechoic lesion on transrectal US
- will also see Michaelis-Gutmann bodies
Sarcoidosis
Extremely rare, only 4 cases reported, must r/o infx
Granulomatous Prostatitis
Subclassified into infx granulomas, nonspecific granulomatous prostatitis, postbx resection granulomas and systemic grnulomatous prostatitis
- MC is nonspecific granulomatous prostatitis, then postbx granulomas
-- infectious and systemic granulomas much more rare
Mycotic Prostatitis
Fungal infx in prostate usually in immunocompromised pts c disseminated dz
- MCC are blasto, coccidio, paracoccidio, and crypto
- are histologically identical to nonprostatic sites
Mycobacterial Prostatitis
Can occur c systemic TB, but usually seen in pts as complication of BCG immuntx for superficial bladder ca
- incidence of prostatic involvement is up to 12%, usually has co-existing pulmonary TB (usually from hematologic dissemination), and much more freq in pts c urogenital TB
- can also occur from M. abscessus infx
If occurs following BCG tx, pts have fever, mild hematuria, and urinary freq, coinciding c abnormal DRE and US abnormalities, and can mimic carcinoma on MRI or PET-CT and have inc PSA
- 1/4 have granulomas and 1/2 have +acid fast stains
- histologically indistinguishable from tuberculous prostatitis from systemic infx
-- small caseating granulomas seen in periglandular stroma, which destroy glands as they enlarge
- large caseating granulomas predominate in the peripheral zone of prostate
- almost always have suburethral granulomas
Nonspecific Granulomatous Prostatitis
MC granulomatous process dx'd in prostate, rare
- MC sx are irritative voiding fx, fever, chills, and obstruction; majority have pyuria, 1/2 c hematuria
- thought to be a rx from bacterial toxins, cell debris and secretions spilling into stroma from blocked ducts
- mimics prostate ca on rectal US and MRI exams, can cause inc PSA
-- histo can also mimic ca
- earliest lesion shows dilated ducts and acini filled c neuts, debris, foamy histiocytes and desquamated epithelial cells
-- rupture of these ducts and acini causes localized granulomatous and chronic inflam rxn
- many of the histiocytes are multinucleated c foamy cytoplasm
- usually in the center of the large inflam nodules are dilated and partially effaced acini
- older lesions have more prominent fibrous component
Usually there is little histologic similarity bwt nonspec granulomatous prostatitis and infx granulomatous inflam of the prostate (must do bug stains)
- granulomas of nonspecific granulomatous prostatitis are not as granulomatous as those seen in infx and have a more mixed inflam infiltrate
- acini usually more intact in infx, and are dialted in nonspecific granulomatous prostatitis
-- nonspec gran prostatitis can have lots of eos, should not confuse c allergic gran prostatitis (eos part of the inflam rxn)
Tx: warm sitz baths, fluids, and abx if pt has UTI
Px: usually resolves in a few months; though can have perisitently abnormal rectal exam
Postbiopsy Granulomas
Prostatic granulomas freq are sequelae after TURP, which can form up to years after a procedure
- made of central region of fibrinoid necrosis surrounded by palisading epithelioid histiocytes
- in contrast to infx granulomas, usually has ghost-like structures of vessels, acini and stroma
- shape is often irregular
- can have lots of eos if TURP done in last month
- asx and do not req tx
Systemic Granulomatous Prostatitis
Encompasses cases c tissue eosinophilia such as allergic granulomatous prostatitis and Churg-Strauss syndrome as well as those w/o eosinophilia such as Wegener granulomatous prostatitis
- must distinguish very rare allergic granulomatous prostatitis, usually c asthma or evidence of systemic allergic rxn at time of dx; and have eosinophilia in PB
Miscellaneous Infections
Rarely, CMV and HSV affect the prostate
- pts in other countries may be affected by schistosomiasis, amoebic prostatitis, syphilis, actinomycosis, echinococcosis and brucellosis
Malakoplakia in prostate

Nonspecific granulomatous prostatitis

Preneoplastic Lesions in the Prostate: Prostatic Intraepithelial Neoplasia (PIN) and Intraductal Carcinoma of the Prostate
Prostatic Intraepithelial Neoplasia (PIN)
First described in 1960s by McNeal as intraductal dysplasia
- consists of architecturally b9 prostatic acini or ducts lined by cytologically atypical cells
- subcategorized into low- and high-grades
-- the difference bwt LG-PIN and HG-PIN is the finding of prominent nucleoli in HG-PIN (nucleoli should be visible at 20x)
LG-PIN consists of preexisting b9 prostate glands c minimal epithelial prolif in terms of nuclear stratification where nuclei minimally enlarged w/o prominent nucleoli
- LG-PIN does not need to be mentioned in the dx(?)
- can have tufting c prolif of crowded nuclei, but w/o nucleoli
HG-PIN has nuclear atypia as well as architectural abnormalities (tho may resemble b9 glands)
- appear basophilic 2/2 nuclear enlargement, hyperchromasia, overlapping and amphophilic cytoplasm
- Flat HG-PIN seen c nuclear atypia w/o epithelial hyperplasia
- usually there is an abrupt transition bwt normal epithelium and HG-PIN, and basal layer may not be present
- interesting feature of HG-PIN is that nuclei toward center of gland tend to have more normal appearing nuclei than the more basally situated nuclei
- the grade of PIN is thus graded by the nuclei closest to the BM
- with more epithelial hyperplasia can see more complex architectural patterns such as Roman bridging and cribriforming
- many subtypes exist
Evidence Linking PIN to Cancer
Prostates c carcinoma have inc in number and size of HG-PIN foci, which also correspond to inc number of multifocal carcinomas
- can sometimes see "transitive glands" (aka HG-PIN c microinvasive ca) where glands c carcinoma are budding off glands c HG-PIN
- HG-PIN more related to peripheral (vs transition zone) ca
Morphologic spectrum from normal prostate to high-grade prostatic intraepithelial neoplasia: A) Normal prostate, B) LG-PIN, C) HG-PIN

Central Zone Histology
Glands in the central zone at the base of the prostate are complex and alrge c lots of papillary infoldings and are often lined by tall pseudostratified epithelium c eosinophilic cytoplasm
- occasionally a prominent basal layer surrounds these glands, whereas in HG-PIN the basal layer is usually indistinct
- central zone glands are frequently dx'd as HG-PIN bc they have nuclei piled up and can be arranged in a Roman bridge and cribriform gland patterns
- of note, the central zone glands have nuclei that stream parallel to the glandular bridges, in contrast to the more rigid bridges seen in HG-PIN
- more importantly, central zone glands distinguished from HG-PIN by their lack of cytologic atypia
Central zone of prostate c Roman bridging
Central zone c cribriform formation


Clear cell cribriform hyperplasia

Crowded tubules of BCH c prominent nucleoli

Clear Cell Cribriform Hyperplasia
Typically seen in the transition zone (vs HG-PIN in peripheral zone) has crowded cribriform glands c clear cytoplasm, sometimes growing as a nodule and in other instances more diffusely
- key distinguishing feature from HG-PIN is the lack of nuclear atypia, and at least some of the glands have a basal cell layer (not seen in HG-PIN)
- immunostaining for abs to basal cells not very helpful since both clear cell cribriform hyperplasia and HG-PIN have patchy basal cell layers
Basal Cell Hyperplasia (BCH)
can have prominent nucleoli c mitotic activity, which can be mistaken for HG-PIN (can be hard to diff)
- basal cell hyperplasia has prolif of small round crowded glands, and in HG-PIN atypical nuclei fill preexisting larger b9 glands separated from each other by a greater amt of stroma
- nuclei in basal cell hyperplasia are round and at times form small solid basaloid nests
- nuclei in HG-PIN more pseudostratified and columnar and do not occlude the glandular lumina
- in areas of basal cell hyperplasia, atypical basal cells seen undermining overlying b9-appearing secretory cells, and the basal cells in these foci have streaming morphology parallel to BM
-- HG-PIN has full thickness cytologic atypic c nuclei oriented perpendicular to the BM
- BCH has HMWK or p63 positivity in multilayered nuclei, tho in some cases the more centrally located cells are not immunoreactive
-- in HG-PIN, HMWK or p63 stain only flat cytologically b9 basal cells under negatively stained atypical cells of PIN
- BCH can also be cribriform, mimicking HG-PIN
BCH c prominent nucleoli

New 5-grade group system (ISUP and WHO, Pierorazio et al. BJU Int 2013; Epstein JI et al. AJSP 2016


Epstein JI et al. Eur Urol 2016 (20,800 men)
Acinar (Usual) Adenocarcinoma
Can be hard to diff cribriform HG-PIN from cribriform Gleason pattern 3 AC in some cases (usually not too critical)
- in the absence of infiltrating glands, infiltrating AC should only be dx'd on H&E when atypical glands are too large, back-to-back or outside the prostate to be called cribriform PIN
- negative IHC for basal cells also consistent c AC, whereas patchy staining more consistent c PIN
A more common scenario where it is difficult to distinguish acinar AC from HG-PIN is when there are a few atypical glands adjacent to HG-PIN (aka PINATYP)
- a dx of ca can be made only if the small atypical glands are too numerous or too far away from the HG-PIN glands to represent outpouching or tangential sectioning form the PIN glands
- in PINATYP the lack of basal cells in the small atypical glands can be construed as evidence that these glands represent infiltrating cancer only if there are more than a few such glands
- as HG-PIN glands can have discontinuous basal cells, may be that tangential sections cut off basal cells
- racemase does not diff HG-PIN and ca bc both are typically + for this ag (ERG should not be used either)
Cribriform glands. Differential is intraductal ca vs cribriform ca. There is a suggestion of a basal cell layer, which in retrospect represents flattened cancer cells. All of the cribriform glands seen in this field as well as in other areas were negative for HMWK. There were too many entirely negative cribriform glands to represent intraductal carcinoma, resulting in a diagnosis of cribriform carcinoma.

Ductal Adenocarcinoma
Hard to diff HG-PIN and ductal AC
- ductal ACs are agressive, advanced stage, and assoc c a poor px
- critical to diff from PIN
- ductal AC usually centrally located in periurethral region and sampled on TURP
-- PIN uncommon in periurethral region and infreq seen on TURP
- ductal AC usually has true papillary fronds c well-formed fibrovascular core, whereas HG-PIN more freq reveals micropapillary fronds c tall columns of epithelium w/o fibrovascular stalks
- ductal AC freq has comedonecrosis, which can be extensive
-- HG-PIN lacks comedonecrosis
- ductal AC can consist of large or back-to-back glands, whereas glands c PIN are of the size and distribution of b9 glands
- use of basal cell markers in the DDx can be problematic as both HG-PIN and ductal AC can have a patchy basal cell layer, however, the lack of a basal cell layer in numerous glands rules out PIN
Although the MC forms of ductal AC mimic cribriform and micropapillary HG-PIN, ductal AC can be composed of simple glands lined by stratified columnar epithelium c cytologic and architectural features of flat and tufting HG-PIN
- these PIN-like ductal cancers are distinguished from HG-PIN either bc the atypical glands are too crowded to represent HG-PIN or there are too many atypical glands that are negative for basal cell markers to be consistent with HG-PIN
- additional differences are in the PIN-like ductal AC, many of the glands are lined by flat epithelium (an uncommon pattern in HG-PIN) and the glands are often cystically dilated
Px: up to 1/2 metastatic at dx
Low-Grade PIN: Risk of Cancer on a Rebiopsy
LG-PIN should not be included in path reports
- lack of reproducibility
- no inc risk of ca on re-biopsy
- thus can lead to unnecessary rebiopsy
Ductal AC

Intraductal carcinoma c dense cribriforming pattern

Same case as left image, showing patchy intact basal layer (p63)

High Grade PIN (HG-PIN) on Biopsy: Incidence, Risk of Cancer on Rebiopsy and a Rebiopsy Strategy
HG-PIN: Incidence on a Biopsy
Marked variation in literature in incidence of HG-PIN on needle bx, from 0 to 25%, mean of 7.6%
- no relation bwt # cores and incidence
- variability may be due to pathologists interpretation of "nucleoli present" to dx HG-PIN
- technical variability may also explain the differences
HG-PIN: Overall Risk of cancer
By contemporary studies, risk of ca on rebiopsy is ~21%; whereas the risk of ca on rebiopsy of a b9 dx is 19%
HG-PIN: Risk of cancer stratified by clinical predictors
Inc serum PSA cannot be caused by HG-PIN by itself, and inc serum PSA does not correlate c risk of ca
- after review, there is no clinical parameter to correlate c ca on re-biopsy
HG-PIN: Risk of Ca stratified by number of cores
The # of cores involved c HG-PIN does correlated c inc risk of ca on re-biopsy
- 30% chance of ca on rebiopsy following dx of HG-PIN in 2 or more cores
- Racemase (AMACR) is upregulated in both HG-PIN and ca
HG-PIN: Repeat biopsy strategy and technique
Wide variation for recommendations in following men c HG-PIN on bx
- may do re-biopsy in 6 mo in men c HG-PIN on 2+ bx cores
HG-PIN: Significance on TURP material
Finding HG-PIN on TURP is more controversial
- may want to do bx on younger men to r/o peripheral ca, and in older men may just want to f/u c PSA levels
Intraductal Carcinoma of the Prostate (IDC-P)
Intraductal spread of a malignant prostatic AC
- frequently assoc c aggressive and high Gleason score invasive acinar adenocarcinoma
- is a prolif of pleomorphoic malignant cells (with nuclear sizes up to 6x nuclear sizes in adjacent invasive adenocarcinoma)
- expands ductal structures, but has at least a partial / patchy basal cell layer (rules out invasive acinar or ductal AC)
- rarely can be id'd on bx material in absence of infiltrating carcinoma
- vs HG-PIN, has a more dense cribriform pattern with overtly more solid than luminal areas (ie ratio of solid to luminal areas >70%)
- may show small cell-like change
- IDC-P on prostate bx is freq assoc c HG ca and poor px at radical prostatectomy
- thus most likely represents an advanced stage of tumor progression c intraductal spread of tumor in most cases
Infiltrating cribriform acinar AC (Gleason 4 or 5 c comedonecrosis) closely mimics cribriform IDC-P
- most cases if IDC-P would be dx'd as cribriform ca if IHC demonstrating basal cells had not been performed
- in some cases, contour and branching pattern of normal duct architecture suggests the dx of IDC-P as opposed to infiltrating ca
- the tx of IDC-P and infiltrating HG-prostate AC are the same, so distinction not critical on bx
- purely IDC-P at radical prostatectomy is 100% cured by surgery, the same may not be true of an infiltrating ca
- if there is no definitive infiltrating ca on H&E sections and a suggestion of IDC-P in a core, then basal stains are recommended to differentiate IDC-P from infiltrating carcinoma
Ductal AC and IDC-P have significant morphologic overlap
- distinguishing features in ductal AC include tall pseudostratified columnar epithelium c amphophilic cytoplasm, classically aranged in cribriform patterns c slitlike spaces and true papillary fronds
- in contrast, IDC-P has cuboidal cells, cribriform patterns c rounded lumina and micropapillary tufts w/o fibrovascular cores
- basal cells are generally absent in ductal AC, although occasionally there may be partial retention of basal cells as ductal AC can also spread within prostatic ducts
Solid patterns of IDC-P can mimic intraductal spread of urothelial ca in the prostate, as both demonstrate solid intraductal-acinar involvement
- other overlapping morphologic features include marked nuclear pleomorphism, freq mits, and comedonecrosis
- however, solid patterns of IDC-P are often assoc c cribriform or glandular patterns
- when it is difficult to distinguish IDC-P from urothelial ca, IHC stains usually resolve the problem, as IDC-P is usually positive for PSA, P501S, and NKX3.1 but negative for HMWK, p63, thrombomodulin and GATA3, opposite to what is usually seen c urothelial ca
The most critical distinction is bwt HG-PIN and IDC-P as the former is typically not tx;d c definitive tx and there is question whether HG-PIN on needle bx even req's immed rebiopsy in the first year after dx
- both entities share similar features (nuclear enlargement, hyperchromasia and enlarged nucleoli)
- loose cribriform and micropapillary patterns overlap bwt the 2 entities
- to est dx of IDC-P should see markedly enlarged nuclei (6x greater than in non-neoplastic cells) and comedonecrosis
- IDC-P is not likely to be pre-invasive in most cases
- whereas HG-PIN is often present in prostates that have not yet developed invasive ca, IDC-P is almost always assoc c invasive ca
- PTEN genomic and PTEN protein loss have been assoc c more aggressive dz
Intraductal carcinoma of the prostate with PIN4 cocktail highlighting basal cells


Intraductal carcinoma of the prostate with PIN4 cocktail highlighting basal cells


PIN Like (Ductal) Adenocarcinoma
Unusual (1.3%) PCA variant cytologically and architecturally resembling HGPIN
Characterized by non cribriform stratified epithelium similar to flat, tufted and/or micropapillary PIN
Greater degree of glandular crowding and/or
disorder than usually seen in PIN
Malignant epithelial cells are columnar or cuboidal
Nuclei are rounded or oval to fusiform
Versus HG-PIN, PIN-like adenocarcinoma:
Presence of cystically dilated glands
Greater predominance of flat architecture
Less frequently prominent nucleoli
Long strips of PIN like epithelium on the edge of
the core
Absence of basal cells
Graded as GS6 (GG1)
PIN-like ductal AC

PIN-like ductal adenocarcinoma, CDX2-, PSA+, p63-

PCA with aberrant p63 expression
Unusual (0.3%) variant of PCA
Tumor cells express p63 in a nonbasal distribution
HMWCK --, CK5/6
76% involving PZ; 86% coexist with acinar PCA
Most tumors are organ confined (76 100%)
No lymph node metastases (12/21 with node
dissection)
No prognostic significance; favorable findings at RP
Ki 67 <5%
It is recommended not to assign a GS and
mention their favorable findings at RP
Osunkoya et al. AJSP 2008; Giannico et al. AJSP 2013
PCA with aberrant p63 expression

p63
.jpg?crc=248525416)
CK5/6
.jpg?crc=3950765590)
Diagnosis of Limited Adenocarcinoma (AC) of the Prostate
Diagnosis on Needle Biopsy
General Principles in Diagnosing Prostate Cancer
2 main issues in dx'ing limited ca on needle bx of prostate
- 1) recognizing limited ca and the prevention of false-neg dx
- 2) lesions mimicking AC of prostate and prevention of false - pos dx
Under-dx'ing limited AC of prostate on needle bx is one of the MC problems in prostate bx
- probably around 2% of cases
- dx of limited AC based on pathologist's experience
- at the edge of most ca, scattered neoplastic glands infiltrate widely bwt larger prostatic tissue
- should try hardest to recognize limited AC, bc cancer on core may be tip of iceberg for ca in prostate
- dx of ca should be based on constellation of features, not just one thing by itself
Architectural Features in the Dx of Cancer
- first should ID normal non-neoplastic tissue
- some prostates have lots of groups of small crowded glands similar to adenosis (should dx ca c caution)
- prostatic atrophy can also be present, and prostatic ca should also be dx'd c caution if atypical glands have scant cytoplasm
Should scan prostate at low power (helps to not overlook ca)
- higher power can be confusing in prostate
- get tipped for AC by seeing groups of crowded glands, esp if next to larger b9 glands
-- b9 glands have papillary infolding and branching
An infiltrative pattern c small atypical glands on both sides of a b9 glands even more diagnostic of malig
- in contrast, mimickers of ca appear infiltrative as collection of glands bwt b9 glands, but do not intercalate as isolated glands bwt and around b9 glands
Another sign of prostate ca is seeing linear row of atypical glands either across the width of core or along edge of core
- linear growth is not a feature of mimickers of AC
Nuclear features in the Dx of Cancer
Prominent nucleoli, though important in dx;ing ca on needle bx, should not be the only criteria used to dx
- prominent nucleoli can be seen c b9 mimickers
- a significant minority may lack prominent nucleoli
- overstained or thick sections can obscure nuclear detail (and thus may be seen better on sections for IHC)
- not useful to eval whether nucleolus is central or not
- hyperchromasia can help diff cancer from b9
- mits are seen in some ca's (~10% esp higher grade ca's) and rarely in b9 tissue (<3%)
- apoptotic bodies, although less common, are more often seen in cancerous glands than b9 tissue
Conventional prostate ca, even when very HG usually has fairly uniform nuclei
- if very poorly differentiated, may consider mets
- PSA typically negative in giant cell component and often only focal in conventional AC component
Cytoplasmic features in the Dx of Cancer
Although often overlooked, cytoplasmic features may be essential in dx'ing prostatic ca
- in some AC, the cytoplasm is more amphophilic than the b9 surrounding glands, which are paler or bluish
- the lack of lipofuscin in atypical prostatic glands may help to push the dx to cancer (lipofuscin uncommon in HG-PIN and rare in AC
- abundant cytoplasm c straight luminal borders in larger glands is also a feature of AC, described as a "pseudohyperplastic ca" (but can be seen in atrophy)
Intraluminal Contents in the Dx of Cancer
Crystalloids are dense red structures in various geometric patterns seen on b9 and malig glands
- presence of crystals inversely related to Gleason score
- more freq in cancer than b9 glands, but can also be seen in the b9 condition, adenosis
Blue-tinged mucinous secretions more common in ca, and rarely seen in b9 glands
- dependent on the H&E stain
Pink, dense amorphous acellular secretions seen in ~1/2 cancer, and only occasionally in b9 glands
- should be distinguished from corpora amylacea, which are well-circumscribed round to oval structure c concentric lamellar rings that are prominent in b9 glands and rare in ca
Histologic features specific for Prostate Cancer
3 features which have not been seen in b9 glands, which are in and of themselves dx'ic of ca
1) Perineural invasion
2) Mucinous fibroplasia (collagenous micronodules)
3) Glomerulations
Mucinous fibroplasia - occasionally intraluminal mucinous secretions are so extensive that they become focally organized
- mucinous secretions can displace the epithelium, resulting in atrophic cytoplasm and small pyknotic nuclei, whereby these foci can be hard to see as ca
Glomerulations - glands c cribriform prolif that is not transluminal, but only attaches to one side of the gland (thus resembling a glomerulus)
Perineural invasion - seen in 20% of needle bx of prostate c AC
- if showing PNI hinges on the dx, glands should surround the nerve completely
- must be distinguished from perineural indentation by b9 glands (only partially encompasses nerve)
-
Id of Basal Cells on H&E stained sections
The problem of id'ing basal cells on H&E is that cases of obvious ca there can be cells that mimic basal cells
- these basal cell-mimickers are neg c HMWK or p63 stains
- can fool you out of the dx of AC if you look too hard
Dx of limited HG- Ca
Inc rate of small HG ca c inc in # bx's
- a focus can be diagnostic of HG AC despite the lack of cytologic atypia, but bc of lack of well-formed glands



Small glands c nuclear hyperchromatism and dense eosinophilic secretions and intraluminal crystalloid (black arrow). Rare prominent nucleoli seen (red arrow)
Small glands c endlarged hyperchromatic nuclei. Note intraluminal eosinophilic and blue-tinged mucinous secretions. Compare c b9 gland (left)

Row of AC going across core, note glands have more amphophilic cytoplasm

Apoptotic body in AC
AC c abundant red and blue tinged mucinous secretions, b9 glands lack secretions
AC c corpora amylacea


AC c mucinous fibroplasia mimicking perineural invasion

AC c glomerulations

Perineural indentation by b9 prostate glands


Intraneural involvement by b9 glands
Carcinomas Mimicking B9 Glands
Some ca can closely resemble b9 glands in architecture or cytology and may not be seen as malig
- IHC may be needed to confirm lack of basal cells

Foamy glands ca can be seen c abundant foamy cytoplasm, c gland crowding or infiltrative glands, usually c pink acellular intraluminal secretions
- though cytoplasm can appear xanthomatous, it does not contain lipid, but empty vacuoles
- nuclear enlargement and prominent nucleoli usually absent
- nuclei are usually small, round and hyperchromatic
- foamy gland ca usually admixed c regular prostatic AC
- can have prominent desmoplastic stromal rxn, which can obscure the ca
- occasional cells may aberrantly express HMWK in non-basal cells
Foamy gland AC


Atrophic AC c large nucleoli
Atrophic prostate ca is rare, and is usually un-assoc c prior hx of hormone tx
- dx determined by: 1) a truly infiltrative process c individual small atrophic glands bwt smaller large b9 glands, 2) concomitant presence of ordinary less atrophic ca, and 3) greater cytologic atypia than that seen in b9 atrophy
Pseudohyperplastic prostate ca - larger glands c brnaching and papillary infolding
- recognition based on closely packed glands c nuclear features more characteristic of AC
- a variant is psuedohyperplastic AC is made of markedly dilated glands c abundant cytoplasm that can be hard to dx as malignant
-- comparably sized b9 blands in this variant either ahve papillary inforldings or are atrophic
-- presence of atypia in malignant glands is also a clue to dx
- may also be termed pseudocystic prostate ca
- can be aggressive
Pseudohyperplastic AC c prominent nucleoli (inset)


Small focus of pseudohyperplastic AC consisting of crowded large glands c papillary infolding
Diagnosis of Ca on TURP
Whereas nuclear features play a prominent role on dx of AC on needle bx, often not helpful to dx LG-ca on TURP
- LG-ca usually lacks large nuclei and prominent nucleoli, and mits rarely seen
- cytoplasmic features usually not helpful bc is pale-clear, similar to b9 glands
- glands are still infiltrative, haphazard or growing in an irregular fashion
B9 prostatic glands tend to grow as either circumscribed nodules c BPH or radiate in columns out from urethra in a linear fashion
- although LG- ca tends to be fairly well-circumscribed, the glands infiltrate for a short distance in different directions out into the prostatic stroma
- glands oriented perpendicular to each other and glands separated by bundles of sm muscle are indicative of an infiltrative process
- glands splitting muscle usually malig, but can be b9
- another feature assoc c ca is that some of the vessels among the ca can show prolif of cells resembling glomus cells
Comparing b9 to malig glands can be helpful
- apical snouts are not useful to diff, as can be seen in both b9 and malig
Cautery artifact can be prominent in TURP material
- extensive artifact around a suspicious focus may preclude a dx of AC, but not always
AC c vessels showing "glomus-like" changes

Use of IHC Adjunctive Tests for Dx of Ca
MC ab to label basal cells is HMWK (aka 34BE12, or CK5/6)
- HMWK staining is limited to cytoplasm of basal cells and is negative in prostate ca
- abs to p63 also label basal cells in b9 prostate
- p40 is a comparable IHC to p63
- p63 may be slightly better than HMWK
- best to try to use IHC when more than a few malig-appearing glands are present
- IHC use on TURP specimens may be better than bx bc more glands are present
- cautery can cause false-neg for HMWK
- if stains for basal cells only neg in small group of glands, be very cautious in dx'ing AC
Uncommonly can see occasional ca cells pos for HMWK and less likely p63, but if these cells not in basal cell distribution likely is aberrant expression
- most of these aberrant cells have atrophic cytoplasm, hyperchromatic nuclei and visible nucleoli
Alpha-methylacyl-CoA-racemase (AMACR)
Enzyme involved in B-oxidation of branched-chain FA's, is significantly upregulated in prostate cancer
- ab's developed against its gene product (P504S protein), in dot-like and luminal fashion
- majority of prostate ca + for AMACR, sensitivity ranging from 82-100%
- AMACR expression may be dec in foamy gland, atrophic and pseudohyperplastic prostate cancers
- negative staining in small suspicious glands not necessarily diagnostic of b9 glands, and positivity also not diagnostic of malig glands (can be in mimickers of prostate ca)
- AMACR can also be aberrantly expressed in HG-PIN, partial atrophy, atypical adenomatous hyperplasia, and nephrogenic adenoma (which is why using the cocktail c HMWK and p63 can in accuracy) [6]
Different cocktails have been investigated combining ab's for AMACR and basal cell specific markers
- one combo is AMACR c p63, may be problematic
- can also try triple stain c HMWK, p63 and AMACR
ERG
For detecting limited AC
- fusion bwt androgen-regulated transmembrane protease serine 2 (TMPRSS2) gene and ERG gene present in ~40-50% of prostate AC, and can be found by ERG IHC
- gene is specific for prostate AC, tho can also be in up to 20% of HG-PIN
- rare b9 glands can express ERG
- has low sens, so negative stain does not exclude AC of prostate
CK903
Useful in distinguishing bladder from prostate ca
- will not be diffusely positive in prostate ca, but only positive in a few cells

Triple cocktail stain c p63 (nuclei brown), HMWK (cytoplasm brown) and AMACR (red). B9 glands (lower left) have basal cells labeled c HMWK and p63. Cancer c AMACR positivity shows brown staining of scattered tumor cells in a nonbasal cell distribution. Note positive tumor cells show cytoplasmic staining only, indicating nonspecific positivity for HMWK and not p63

Triple immunostain in the diagnosis of prostate adenocarcinoma. A small focus of prostatic adenocarcinoma is showing in the lower part of the core (A) and highlighted by overexpression of a-methylacyl coenzyme A racemase (red chromogen) and lack of basal cells demonstrated by negative immunostain of p63 and high-molecular-weight cytokeratin (HMWCK) (B). Adjacent benign glands (B) show basal cell stain for p63 (nuclear) and HMWCK (cytoplasmic) [6]

[6]
Mimickers of AC of the Prostate
Mimickers of Gleason Score 2 to 6 AC
Adenosis
aka atypical adenomatous hyperplasia (AAH)
- very little data showing relation bwt adenosis and ca
- the term "atypical" may lead to unnecessary re-bx
- also no evidence showing that it is a precursor to ca
Wide spectrum of reported incidence of adenosis on TURP, from 2 to 20%
- crowded b9 glands c absent of patchy staining for basal cell markers and/or pos racemase pos are some of the more freq mimickers of prostate ca
- dx of adenosis should be restricted to cases c sufficiently atypical growth pattern such that you must consider dx of LG ca
- bc more freq in transition zone, adenosis seen more freq on TURP than on needle bx
- however, adenosis seen in ~1% of needle bx
- usually not in the pathologist's diff, but should be considered as it is relatively frequent
Ddx of adenosis from LG-AC based on architectural and cytologic features
- the constellation of features, rather than a single feature, should be used in making the dx
- adenosis can have small visible nucleoli
Adenosis c slight papillary infolding and readily identifiable baal cells (arrows). Basal cell nuclei have a more gray appearance rather than red-violet of secretory cell nuclei




AC mimicking adenosis. Glands of AC showing enlarged nuclei c prominent nucleoli (arrows) in contrast to adjacent b9 glands (lower left)

Crowded glands of adenosis on needle bx. The glands appear similar in nuclear and cytoplasmic features to adjacent b9 glands (lower right and upper left areas of upper left panel). Glands of adenosis mimicking ca. Small glands merge in c more recognizable b9 glands (upper left). Note more b9-appearing glands c papillary infolding contains a dense intraluminal eosinophilic crystalloid. Adenosis c b9 cytologic features (bottom left panel). Adenosis c scattered glands c patchy basal cell layer. Negatively stained glands identical in their morphology to those that contain a patchy basal cell layer

AC mimicking adenosis. Note small glands c enlarged nuclei c more prominent nucleoli as compared to adjacent b9 glands (lower left and upper right). AC mimicking adenosis shows small b9 glands that are entirely neg for HMWK. Note b9 gland c basal cells (left). In adenosis, at least some basal cells would be in such a focus.
Probably the most important differentiating feature of adenosis seen on H&E inthat in a nodule of adenosis there are elongated glands c papillary infolding and branching lumina typica of more b9 glands, yet in their nuclear and cytoplasmic features, they look similar to the adjacent small glands suspicious for ca
- another common feature seen is budding off of glands of adenosis from obviously b9 glands
- glands of AC, even in the unusual case when the tumor is fairly lobular, shows a pure population of small crowded glands w/o b9 architectural features that do not merge in with adjacent b9 glands
At higher power, adenosis is typically made of small glands c pale to clear cytoplasm, as opposed to some carcinomas that have more amphophilic cytoplasm
- for this to be useful, the cytoplasm of b9 prostate glands should appear pale or clear on routinely stained slides
- dx of ca should not be done on a few individual cells or poorly formed glands in a nodule otherwise typical of adenosis
- occasional single cells or poorly formed glands are not uncommon in a nodule of adenosis and probably represent tangential sections of small glands
Most cases of adenosis (~60%) have no or rarely prominent nucleoli, the other 40% have fairly prominent nucleoli, which should not lead to dx of ca
- only huge nucleoli (>3 microns) inconsistent c dx of adenosis
- majority (70%) of foci of LG AC have occasional or freq large nucleoli
- thus there is some overlap bwt the 2 entities
Luminal content can also help in the diff
- corpora amylacea typical in adenosis and rare in ac
- only 2% of adenosis have blue intraluminal secretions on H&E
- mucin stains are not helpful
- crystalloids should not be used to diff adenosis from ac (too much overlap)
The presence of basal cells is seen in adenosis and not typical of AC
- a flat basal layer should be in at least some of the glands
- important to distinguish basal cells from adjacent fibroblasts, which have elongated, pointed hyperchromatic nuclei or cigar-shaped nuclei c chromatin similar to overlying secretory cells
If architecture favors adenosis, but there are visible nucleoli, IHC can help diff (HMWK or p63)
- be careful bc some adenosis express racemase
Adenosis often multifocal, and can be esp prominent on TURP, leading to dx of stage T1b, leading to unwarranted radical tx
- even a single focus of ca on TURP can lead to unnecessary tx, esp in younger men
No inc risk of AC from adenosis
- closer to BPH than AC
- the only risk c adenosis is dx'ing the pt c AC and overtreating b9 dz


Nodule of adenosis on needle bx c luminal undulations and some c corpora amylacea typical of b9 glands

AC mimicking adenosis. Multiple prominent nucleoli (arrows) raise the question of AC
Diffuse Adenosis of the Peripheral Zone (DAPZ)
In younger pts, multiple foci of small, nonlobular, crowded but bland acini on needle bx
- can mimic LG-AC, esp if it has rare acini c cytologic atypia
- may be assoc c inc risk of AC, usually seen in DAPZ c focal cytologic atypia
- pts should be followed closely and re-bx'd

PAH c central dilated acini surrounded by smaller atrophic glands

Sclerotic atrophy c rare nucleoli (arrow)

B9 atrophy surrounded by sclerosis

Atrophy c mitotic figure


partial atrophy
Partial atrophy (top) adjacent to more fully developed atrophy (bottom)
High power showing glands c glands of partial atrophy having scant apical cytoplasm and subtle luminal infoldings

Atrophy
Although considered a process of the elderly, has been seen in up to 70% of men 20-30 yo
- causes hardness of prostate or hypoechoic lesion on transrectal US and may be bx'd for fear of ca
Different types of atrphy: simple atrophy, postatrophic hyperplasia (PAH), and partial atrophy
Simple atrophy - at low power looks basophilic 2/2 lack of cytoplasm both apically and laterally vs normal epithelium
- glands c simple atrophy are of normal caliber and are generally spaced apart in a configuration similar to normal epithelium
- in simple atrophy c cyst formation, the acini are round and appear cyst-like, and have acini in back-to-back configuration c little intervening stroma
Postatrophic hypertrophy (PAH) - basophilic at low poer, acini small mostly round in lobular distribution
- acini usually surrounded by dilated "feeder" ducts
- looks like normal-looking resting breast lobules
- appears hyperplastic bc the close packing of multiple small acini suggest inc number vs normal tissue
- PAH has much higher rate of prolif than nonatrophic b9 glands, and mits can sometimes be seen
- although the glands can look infiltrative, they look infiltrative as a patch and not as individual glands infiltrating bwt larger glands
- look basophilic from scant cytoplasm and nuclear crowding
- can have assoc fibrosis, making it look more infiltrative (previously called sclerotic atrophy)
Compared to atrophy, gland-forming AC usually have more cytoplasm, and are thus not as basophilic at low power and are usually more amphophilic
- atrophy can have large nuclei, prominent nucleoli, though not the huge eosinophilic nucleoli seen in AC
- prominent nucleoli in atrophy more assoc c inflam
- inflam in atrophy can also cause some cytologic atypia
- atrophic cytoplasm should cause some hesitation in dx'ing ca
- if in doubt, can de HMWK or p63 for basal cells
- as opposed to partial atrophy, PAH uncommonly expresses racemase
Partial atrophy - MC mimicker of prostate cancer
- can still have the lobular pattern of PAH or have a more disorganized diffuse appearance
- lacks the basophilic appearance of a more fully developed atrophy (simple atrophy or PAH) bc the nuclei are more spaced apart
- crowded glands c pale cytoplasm can lead to over-dx of LG-AC
- higher power shows more b9 appearance, c undulating luminal surface c papillary infolding (most ca's have straight or luminal borders)
- the glands c partial atrophy can have nuclei that are the full height of the cytoplasm, and usually have more b9 nuclear features (no prominent nucleoli)
- should hesitate to dx ca if nucleus is the height of the cytoplasm
- similar to adenosis, partial atrophy has a patchy basal cell layer and expresses racemase
Atrophy and assoc inflam may be assoc c prostate carcinogenesis
- atrophy of all types are very common on needle bx and are not assoc c inc risk of ca or PIN on subsequent bx
Basal Cell Hyperplasia (BCH)
May be called "fetalization" or "embryonic hyperplasia" bc resembles the prostatic acini seen in the fetus
- MC form of BCH is tubules or glands c piling up of BC layer
- BCH is not uncommon in BPH
- glandular-stromal nodules, c lots of glands c BCH can be seen, usually not confused c ca if is well-circumscribed, has abundant stroma, and glands of BCH intermingled c normal glands
- if BCH more florid, can be confused c AC
- can be esp confusing if BCH loses its lobular structure, as in TURP specimens
- at low power, BCH basophilic from multilayering and have scant cytoplasm (vs AC which has more cytoplasm and look more eosinophilic at low power)
- BCH can have cribriform, or pseudo-cribriform glands, which is usually adjacent to more normal glands of BCH
- BCH can have well-formed lamellar intraluminal calcifications similar to corpora amylacea (rarely seen c ca)
- BCH can also have intracytoplasmic eosinophilic globules (hyaline globules)
- bwt glands of BCH are usually unremarkable sm mucles or a minimally myxoid stroma, but rarely a desmoplastic rxn
Basal cell lesions usually in transition zone and usually seen on TURP
- BCH not too common in peripheral zone, so not seen on needle bx too often
- difficult to appreciate the lobular growth pattern on needle bx (easier to see on TURP)
- while some glands in AC may have multilayering, all the glands in BCH have this features
- BCH can have prominent nucleoli, and have fairly prominent nuclear pleomorphism
- if there is uncertainty in the dx, can do IHC, which usually has strong positivity for basal cell markers
- racemase typically negative in BCH
- if a distinct nodule of basaloid nests are formed, can use term basal cell adenoma or adenoid basal cell tumor, but should still consider these lesions as more pronounced examples of BCH
BCH c glands c multilayered nuclei and atrophic cytoplasm




BCH c numerous hyaline globules
BCH c focal pseudocribriform formation, glands appear more back-to-back than true cribriform
Colonic Mucosa
Rarely. distorted frags of colon on transrectal bx can be confused c AC
- features of b9 colon that mimic prostatic AC: blue-tinged intraluminal mucinous secretions, prominent nucleoli, mits, extracellular mucin, adenomatous changes of rectal tissue
- IHC will also make you think that it is prostate AC, bc normal colon does not have a basal cell layer and is racemase positive
- clues that can help you decide that it is b9 colon is the presence of lamina propria, rectal tissue on a detached frag of tissue, assoc inflam, goblet cells, and muscularis propria
Cowper Glands
Initially Cowper glands found on TUP as pitfall in dx of prostate ca, but can be seen on needle bx
- particularly mimic foamy gland ca, which usually has bland cytology
- presence of glands in sk muscle can further mimic ca if not id'd as Cowper glands
- dx of Cowper glands relies on recognition of noninfiltrative lobular pattern of a dimorphic population of ducts and mucinous acini in Cow[er glands c caveat that the ducts may not be obvious in all foci
- Cowper glands have distended rounded cells that are expanded to the point that glandular lumina often totally or subtotally occluded (foamy gland ca lack globoid cells and have well0formed open lumina c dense pink secretions
- presence of abundant mucin-filled cytoplasm also distinguished from ca
- IHC can be helpful in hard cases: PSAP is always negative (though abundant cytoplasm of acinar cells can stain c PSA in heterogeneous "clumped" fashion)
- ductal epithelium does not react c either ab
- HMWK highlights the ductal epithelium, hybrid cells and attenuated basal layer at the periphery of acini
- Muscle-specific actin (MSA) can be pos in basal distribution vs neg in prostate ca

Colonic mucosa mimicking AC prostate, notice the goblet cells

Colonic mucosa on needle bx c triple cocktail stain showing lack of HMWK and p63 and positive AMACR mimicking prostate ca

Cowper gland, note muscle (left) and dimorphic pattern c scattered atrophic ducts among acini lined by mucinous cells

Cowper gland c mucin-filled ovoid goblet cells almost occluding the lumina of the acini

HMWK staining Cowper gland ducts and periphery of mucin-filled glands (arrows)
Mesonephric Remnant Hyperplasia (MRH)
Very rare b9 mimicker of AC that is identical to the lesion seen in the femal genital tract
- negative for PSA and PSAP
- HMWK diffusely + in 1/2, c partial + in remaining 1/2
- p63 was largely negative
- all were PAX-8 diffusely pos
- usually seen in the anterior fibromuscular stroma and adjacent anterolateral periprostatic tissue or in the base porsteriorly and posterolaterally either in or exterior to the prostate and around the seminal vesicle
- usually see small to med-sized acini or tubules in a lobular distribution (in all cases), can have cysts either in clusters or scattered containing secretions, small or ill-formed glands c infiltrative growth, glands c papillary infoldings or micropapillary tufts
Mesonephric hyperplasia

Nephrogenic Adenoma
Condition rarely seen, usually in prostatic urethra
- extension of small tubules of nephrogenic adenoma into underlying prostatic fibromuscular stoma can lead to misdiagnosis of LG-AC of prostate in TURP and rarely on bx
Seminal Vesicles
Seen in ~3% of TURPs
- may be assoc c postop-epididymitis if resected
- may resemble AC
- seminal vesicles have central large dilated lumina c lots of small glands clustered around the periphery
- usually the glands appear to bud off from the central lumen
- can be difficult to appreciate the architectural features on needle bx, but may see a dilated irreg lumen at the edge of the tissue core where the core has fragmented as it entered the seminal vesicle lumen
- surrounding the dilated structure are clusters of smaller glands (recognizing this feature is helpful in the diff of AC from normal seminal vesicles)
- at higher power, seminal vesicle epithelium usually has prominent nuclear atypia
- nuclei are markedly enlarged c bizarre shapes and ahve marked hyperchromasia that obscures nuclear details
- despite marked pleomorphism, the cells lack mits
- the atypia seems degenerative in nature, similar to radiation atypia
- the degree of nuclear atypia in seminal vesicles is usually too severe for that usually seen in prostate ca (which usually only has slight to moderate atypia)
- even poorly diff prostatic AC only has moderate nuclear atypia
- seminal vesicles usually have prominent globular golden brown lipofuscin granules, whereas prostate has smaller granules that are more red-orange or blue and are less common in prostatic AC
IHC can help settle any problems, as basal cells will be highlighted in seminal vesicle with CK903 and p63 (are AMACR negative)
- seminal vesicle epithelium is CK7 positive, and negative for PSA and p63 (prostate cancer is CK7 negative and PSA positive)
- PSA and PSAP can rarely label seminal vesicle tissue, so be careful

Seminal vesicle epithelium c scattered markedly atypical hyperchromatic degenerative-appearing nuclei. Note abundant lipofuscin pigment
Verumontanum Mucosal gland Hyperplasia (VMGH)
Verumontanum found on posterior prostatic urethral wall and is the point where the urticle and ejaculatory ducts merge c the prostatic urethra
- VMGH particularly evident at low power, where small size and crowded nature of verumontanum mucosal glands can simulate LG-AC
- can be esp confusing if VMGH seen in multiple cores or if extensively involves a single core
- corpora amylacea is a typical feature of VMGH (not usually seen in AC)
- VMGH usually has characteristic brown-green concretions
- verumontanum mucosal glands stain similarly to prostatic acini


VMGH on needle bx c crowded glands c gray-green intraluminal concretions
Verumontanum mucosal gland hyperplasia c rust-colored concretions (top) and papillary fronds (bottom)
Mimickers of Gleason Score 7 to 10 AC
Clear Cell Cribriform Hyperplasia
Occurs in transition zone, mostly in TURP for urinary obstructive sx and rarely needle bx
- some consider it a cribriform variant of BPH
- made of numerous cribriform glands separated from each other by modest amt of stroma in pattern of nodular hyperplasia
- if florid, can infiltrate stroma diffusely and have back-to-back glands
- if misdiagnosed, would be Gleason 4+4=8
Micro: epithelial cells have clear cytoplasm and small bland nuclei c inconspicuous or small nucleoli
- around man of the glands is a strikingly prominent basal cell layer c row of cuboidal darkly stained cells beneath the clear cells
- basal cells may form small knots at the periphery of some of the glands
- basal cells can occasionally have small nucleoli
- basal layer may also be inconspicuous or incomplete
- although usually unnecessary, HMWK stains basal cells
Distinguishing bwt clear cell cribriform hyperplasia and cribriform PIN can be difficult
- easier to diff from ca, which doesn't have basal cells
- clear cell cribriform hyperplasia probably unrelated to AC

Clear cell cribriform hyperplasia
Nonspecific Granulomatous Prostatitis (NSGP)
Can closely mimic ca clinically
- bx usually taken in these cases bc cancer suspected, PSA levels usually inc, and DRE abnormal
- though rare, it may resemble prostate ca histologically, c epithelioid histiocytes c large nucleoli and lots of granular cytoplasm, and may have cribriforming
- key to avoid misdiagnosis of ca is to find the other inflam cells, like neutrophils, lymphs, plasma cells and eos (most ca's lack inflam component)
- 1/2 of cases of NSGP lack MNGCs
- IHC can help id these cells as histiocytes, and they will be neg for PSA, PSAP, panCK

NSGP mimicking prostate ca. Sheets of epithelioid cells some c nuclei showing prominent nucleoli (arrows)
Paraganglia
Seen in 8% of radical prostatectomies
- usually present in posterolateral ST exterior to the prostate
- can uncommonly be found in lateral prostatic stroma or in bladder neck sm muscle
- consist of a cluster of clear or amphophilic cells c fine cytoplasmic granules and prominent vascular pattern, often intimately related to nerves
Small, solid nests of cells with clear or amphophilic finely granular cytoplasm
- nucleoli are occasionally prominent, and if present assoc c degenerative nuclear atypia
- paraganglia are found in sm muscle, and not mixed c b9 prostate glands
- although can mimic HG-ca, the highly vascular setting and degenerative atypia are clues to prevent misdiagnosis
- thus, should consider this entity b4 dx'ing a small focus of HG-ca where the atypical focus is entirely extraprostatic
Often with a “zellballen” arrangement
IHC:Chromogranin+, NSE+, S-100+, synaptophysin+,
- neg for PSA and PSAP

Paraganglia
Paraganglia


Paraganglia: S100+

Paraganglia: Hyperchromatic nuclei, inconspicuous nucleoli
Paraganglia vs High-grade PCA

More paraganglia

Sclerosing Adenosis (SA)
- used to be called adenomatoid prostate tumor
May be in up to 2% of prostates
- usually seen in TURP specimens for obstruction
- usually only 1 or 2 small foci are present, though can be many
- as in any TURP specimen, cannot distinguish multifocality or multiple sections through single lesion
- must diff from AC
- sclerosing adenosis has mix of well-formed glands, single cells and cellular spindle cell component
To prevent misdiagnosis of malig:
1) AC usually is an extensive process, finding only a small region should lead you to consider sclerosing adenosis or paraganglia
- although sclerosing adenosis is usually well-circumscribed, may be minimally infiltrative at perimeter
2) Glands in sclerosing adenosis resemble those of ordinary adenosis, and are made of cells c pale to clear cytoplasm, and b9-appearing nuclei
- many of the glands have visible basal cells
3) SA has dense spindle cell component not seen in AC, stromal cells plump fusiform cells c amphophilic cytoplasm; stroma has myxoid appearance
- AC usually does not have stromal response or at most a hypocellular fibrotic rxn
4) Has hyaline sheath-like structure around some of the glands
- the glands in AC lack such a collarette and have a "naked" appearance as they infiltrate the stroma
5) the bland cytology of SA helps distinguish from AC, though some glands in SA can be moderately enlarged and have prominent nucleoli
IHC:- S-100 + basal cells
Signet Ring Lymphocytes
TURP can show lymphs c signet cell morphology
- may be 2/2 thermal injury and not seen in needle bx or open prostatectomy specimens
- is only rarely confused c signet ring ca

Sclerosing adenosis on needle bx. Note hyaline sheath around some of the glands and individual cells (arrow)
Xanthoma
Rare, but can cause confusion, esp in small tissue frags such as in needle bx
- most cases only have one focus of xanthoma
- xanthoma cells have small uniform, b9-appearing nuclei
- small inconspicuous nucleoli and abundant vacuolated foamy cytoplasm c no mits
- though usually arranged in circumscribed solid nodular pattern, can also form cords of cells that infiltrate the prostate stroma, mimicking HG-ca
- IHC c CD68 (pos) and CAM5.2 (neg) helps in the dx of prostatic xanthoma in difficult cases c infiltrative pattern

multifocal xanthoma on needle bx
Reporting Cancer: Influence on Prognosis and Treatment
Needle Biopsy
Use of Macros (canned text)
Can be useful to save time and reduce errors, and for research purposes, but should not be too heavily relied upon
Quantification of Amount of Cancer on Needle Bx
Can quantify by # cores pos, millimeters of ca, % pos, total % of ca in entire specimen
Prediction of Pathologic Stage and Margins
- fraction of pos cores, number of positive cores and percent ca on bx may correlate c stage and margins
- can use nomograms to factor in needle bx tumor vol to predict stage in pretreatment PSA, bx Gleason score, and percent pos cores
- having >3 sextant cores c Gleason 4 or 5 has 45% chance of nodal mets
Prediction of Posttreatment Progression
- can be predicted using percent pos cores, Gleason score, PSA, and clinical stage
Prediction of Prostatectomy Tumor Volume and Potentially Insignificant Tumor
- can predict tumor volume using measurements from needle bx
- however, limited amts of ca on bx do not necessarily correspond to limited ca on core
- better predictions occur when measuring the b9 tissue bwt ca on cores
Predicting Extraprostatic Extension into Neurovascular Bundle (NVB)
- critical decision either before or during surgery is whether to spare NVB to preserve potency or to resect it in cases c high risk of extraprostatic extension
- frozen sections of region around NVB may not be helpful; palpation by an experienced urologist during surgery may be more helpful
- PSA >10, side-specific Gleason score, and amt of involvement by tumor may predict NVB involvement
Location of Positive Biopsy Cores
may be important to know where bx core came from in up to 10% of cores that are atypical or suspicious
- several other advantages in submitting cores separately: RT planing, precise re-biopsy, helps recognize dx pitfalls (seminal vesicle or Cowper glands), reduced fragmentation
Needle Biopsy Perineural Invasion (PNI)
PNI is one of the major mechs of extension of ca from the prostatic parenchyma to periprostatic soft tissue
- tho, may not be helpful, who knows? :\
- multiple problems in studying the effects of PNI from a reporting standpoint
Use of Nomograms
Can predict stage and postradical prostatectomy progression
- use Gleanson score, clinical stage, PSA, and extent of ca on bx to present dz
- the Partin tables and Kattan nomograms are the most widely used
Direct Staging on Needle Bx
Sk muscle mixes c normal (non-neoplastic) prostate esp distally (apically) and anteriorly
- this b9 finding can sometimes be seen on TURP or needle bx, and should not be confused c AC
- not common to dx EPE on needle bx (as infiltrating to fat)
- AC can sometimes be seen infiltrating thick well-formed sm muscle bundles suggestive of bladder neck muscle
- ganglion cells sometimes in normal prostate and not indicative of invasion
- must be careful dx'ing invasion into seminal vesicles
EXTRAPROSTATIC EXTENSION (EPE)
Tumor beyond confines of gland
• Admixed with periprostatic adipose tissue; easily recognized in posterolateral, posterior, lateral regions
• Tumor in skeletal muscle does NOT constitute EPE
• Extent ( nonfocal ) and location of EPE tshould be documented
TURP
less ca's dx'd on TURP than before, 2/2 use of medical therapy to tx BPH, alternative surgical methods that do not get tissue
- ca found unexpectedly in TURP known as T1a or T1b dz when tumor very focal, if infiltrative but does not cause induration or if tumor is anterior or central and not detected on DRE
Subclassification
~16% of TUPRs for BPH find incidental AC
- can be stage 1a (LG) or high-vol and high-grade (1b, >5% of the specimen)
- important to accurately stage 1a or 1b, as it changes tx and px

PROSTATE CANCER STAGING (AJCC 8TH EDITION)
(Nguyen DP et al. J Urol 2018; Bhindi B et al. J Urol 2017; AJCC 8 th edition)


EXTRAPROSTATIC EXTENSION (EPE)

staging pitfall - LASOP 2021

SEMINAL VESICLE INVASION
Tumor invades muscular wall of extraprostatic portion of seminal vesicles


SURGICAL MARGIN INVOLVEMENT (+SM)
• Tumor extends extraprostatic or intraprostatic) to prostate inked surface
• For +SM document:
- Location
- Extent (limited: <3 or non limited: ≥3 mm; linear length of SM)
- Gleason pattern @ +SM: pattern 3, 4, 5

Grading Prostatic Adenocarcinoma (AC)
History
Donald Gleason made the system in 1966
- based solely on architecture
- Gleason scores were a set of 2 numbers, the first being the major pattern and the second the minor pattern, ranging from 2 (1+1) to 10 (5+5)
- 4+3=7 does worse than 3+4=7, and was thus called 7b (vs 7a for 3+4=7)
2005 Intl Soc of Urological Path Modifications
- in the 60's, pts usually presented with advanced prostate ca at dx, and prostate bx was usually done taking some larger bx's from a palpable area
- sextant needle bx's weren't used until the late 80's
At the 2005 USCAP meeting, 70 urologic pathologists convened to modify the Gleason grading system
General Applications of the Gleason Grading System
- Should first assess the grade at low power, then move to higher power to verify
- best way to report Gleason grades is using the mathematical eqn (ie 4+4=8)
IMPACT OF MODIFIED GLEASON GRADING SYSTEM
GS6 is lowest score on PBx (confusing for patients and clinicians)
Current GS6 has little propensity to recur or metastasize
Several morphologies previously considered pattern 3 are currently assigned a pattern 4
- GS6 tumors have decreased
- GS7 tumors have increased
Inter observer reproducibility and Bx PR concordance have improved
GS7 includes patients with different prognosis:
- 3+4=7 have better prognosis than 4+3=7
• Provides clearer labels for patient understanding
• Defines a more homogenous low risk group (i.e. Grade Group 1)
• Distinguishes Grade Group 2 ( 3+4=7 ) (AS eligible) from Grade Group 3 ( 4+3=7 ) (AS non eligible)
• Provides greater discrimination in prognosis than traditional Gleason classification


Diagnosis of GS 2-4 PCA should NOT be made on needle Bx because: 1) Poor reproducibility, 2) Poor correlation RP
grade
- GS 2-4 PCA may misguide clinicians/patients into believing that tumor is indolent
*** Most GS 2-4 diagnosed in the past represented adenosis
New 5-grade group system (ISUP and WHO, Pierorazio et al. BJU Int 2013; Epstein JI et al. AJSP 2016

Gleason patterns
Gleason Patterns 1 and 2
Fairly circumscribed nodules of closely packed glands
- glands are uniform in size and shape c slightly more variation in pattern 2 than 1
- Gleason scores of 2 to 4 should not be reported 2/2 poor reporoducability amongst experts
- pathologists are not very likely to report the low Gleason patterns 1 or 2 nowadays
- LG ca rarely seen on needle bx bc are predominantly anterior in prostate in transition zone and are usually small
Gleason 1 and 2 both usually have lots of pale eosinophilic cytoplasm
Gleason pattern 2

Gleason Pattern 3
Has variably sized glands that are well formed
- the glands are discrete units (should be able to mentally draw a circle around well-formed individual glands)
- should be able to assign Gleason grade at low power
- Gleason 3 are either: infiltrative bwt b9 glands, more variably sized or smaller than Gleason 1 and 2
- greater amts of ca on needle bx correlate c larger tumors that are more likely to have areas of pattern 4 at radical prostatectomy
- vs the original drawings by Gleason, cribriform glands are assigned Gleason 4
- some glands will be tangentially sectioned, so the presence of a few glands that do not appear well-formed does not necessarily indicate Gleason 4
- when glands surround a nerve they get a more complex papillary, crowded appearance (be careful about dx'in Gleason 4 in this case)
- mucinous fibroplasia can also resemble fused cribriform glands, but they are really just grade 3
Gleason pattern 3 - small well-formed glands, branching is allowed


Gleason pattern 3 c occasional glands w/o visible lumina (arrows) representing tangential section of adjacent well-formed glands

Gleason 3 - Well formed individual glands, discrete unit Variation is size and shape (microcystic and pseudohyperplastic, Branching glands are allowed in pattern 3 [Paner. Arch Pathol Lab Med (2019)]

Gleason Pattern 4
Fused glands, cribriform glands, and hypernephroma pattern (tho Dr Zhou says hypernephroma should not be used per ISUP2014/WHO2016...)
- also includes ill-defined glands with poorly-formed glandular lumina
- hypernephromatoid pattern closely resembles renal cell carcinoma
- may be hard to distinguish bwt cribriform glands of pattern 4 from poorly formed glands c barely identifiable acini best characterized as pattern 5
- despite the cribriform pattern. Gleason 4 can be cytologically bland
- cribriform pattern 4 glands on bx can look rounded irregularly and shaped c ragged borders
- on needle bx, cribriform Gleason 4 usually manifests as frags of cribriform tumor bc there is little supporting stroma in larger cribriform glands
Cribriform prostate ca glands span a broad spectrum in terms of differentiation
- can be a well-formed gland c well-formed lumina
- less diff have lumina that are not as open
- if cribriform is not well-diff and barely recognizable, may be a Gleason 5
Glomeruloid glands resemble a renal glomerulus
- have a single point of attachment
- usually Gleason 4 or higher
- may be an early form of cribriforming
- a mimicker is telescoping of neoplastic glands
Another Gleason 4 pattern is poorly formed/ fused glands
DIAGNOSIS OF "POORLY FORMED GLANDS" GLEASON PATTERN 4
(Zhou M et al. Am J Surg Pathol 2015)
Definition
Cancer glands with no or rare lumens
Elongated compressed glands
Elongated nests
Consensus diagnosis (>70% agreement) was correlated with quantitative (≤5, 6 10, >10 glands)
and topographic features (clustered, immediately adjacent to, and intermixed with other well formed
glands)
Poorly formed glands immediately adjacent to well formed glands regardless of number, and small foci of ≤5 poorly formed glands regardless of location
were not graded as GP4
Large foci of >10 poorly formed glands not immediately adjacent to well formed glands were graded as GP4
REPORTING % PATTERN 4 AND CRIBRIFORM MORPHOLOGY
- ISUP 2014 recommended reporting %GP4 in GS7 tumors (implications for surveillance, XRT)
- 3_4=7 PCA pattern 4 assic c low-risk tumor on RP
- Cribriform morphology associated with adverse outcome
A Prostate Cancer " Nimbosus ": Genomic Instability and SChLAP1 Dysregulation Underpin Aggression of Intraductal (IDC) and Cribriform (CR) Subpathologies
Chua MLK et al. Eur Urol 2017
IDC/CR+
- Independently predicted increased risk of BCR and
metastasis
- Increased % of genome alteration and hypoxia
- SChLAP1 was only gene expressed >3 fold higher in IDC/CR+ than IDC/CR
Nimbosus ": A constellation of unfavorable molecular characteristics co occur with intraductal and cribriform subpathologies in PCA
Gleason pattern 4


Gleason pattern 4+3=7

Gleason 4. Cribriform (small & large),
Fused, Poorly formed, Glomeruloid glands
Gleason 4 patterns

nimbosus

GP4 large cribriform and fused glands - Large cribriform growth pattern identifies ISUP grade 2
prostate cancer at high risk for recurrence and metastasis
Hollemans et al. Mod Pathol 2019)

MODIFIED GP4 GLOMERULOID & SMALL CRIBRIFORM

MODIFIED GP4 POORLY FORMED GLANDS

Gleason Pattern 5
Consists of sheets of tumor, individual cells and cords of cells; less commonly can have nests of cells
- may be underscored by pathologists
The size of the nest matters!!
- large nests c >20 cells c uniformly distributed nuclei can be called Gleason 5
- medium sized nests c 10-20 cells per nest should not be called Gleason 5
Solid nests of cells c vague microacinar or only occasional gland space formation still consistent c Gleason 5; single cells also Gleason 5
- relatively uncommon pattern is comedonecrosis c solid nests
- comedonecrosis has intraluminal necrotic cells and/or karyorrhexis, esp in cribriform glands
- sometimes there is eosinophilic material in glands that can look like comedonecrosis, but isn't, so don't call it Gleason 5
- small nests and cords of cells can be seen, and sometimes can be confused c urothelial ca, whereas cords are not seen in urothelial ca

Gleason 5+5=10
Gleason 5: Small solid cylinders, Solid medium to large nests with rosette like spaces,
Unequivocal comedonecrosis,
Single cells

G5

Poorly differentiated PCA: PSA+, P501S+, GATA3-, NKX3.1+

Gleason pattern 5. (Gottipati et al. Am J Surg Pathol 2012)

Single cells in gleason 5; two subtypes

Comedonecrosis, G5 and IDC-P. (Fine et al. Am J Surg Pathol 2018)

Grading variants of Prostate Ca
from LASOP 2021 Cristina Magi
Galluzzi, MD, PhD

AC c vacuoles
AC of prostate can have clear vacuoles that differ from true signet-ring cell ca that have mucin
- tumors should be graded as if vacuoles are not present, bc can be found in Gleason grades 3 to 5
Foamy gland ca
Should ignore the foamy cytoplasm and grade the tumor solely based on underlying architecture
- foamy gland ca MC c Gleason score 7 tumor
- an unusual variant for foamy gland consists of widely separated foamy glands assoc c prominent desmoplastic stroma; these tumors are aggressive and are high grade despite relative paucity of malignant glands
Foamy high grade prostatic ca

Pseudohyperplastic AC
- should be graded as Gleason 3+3=6 c pseudohyperplastic features
- can be Gleason grade 4 if it cas assoc cribrifroming
Reporting Gleason grade on bx
Different Cores c Different Grades
- should go with the highest grades on the cores for the final report, bc correlates better c findings at radical prostatectomy
- should report the highest grade as the second score even if it is only a very small percent of the tumor (assuming it is not the dominant grade)
Finding Atypical Glands Suspicious for Cancer
Atypical hyperplasia is nonspecific and encompasses PIN, adenosis, and foci suspicious for infiltrating ca
- should not really use this term
Atypical Small Acinar Proliferation (ASAP) - has been proposed, may refer to HG-PIN, b9 mimickers, reactive atypia, other worrisome glands
- urologists equate ASAP c HG-PIN, though they usually take longer to re-bx, and only ~1/2 of pts do get re-bx, even if re-bx is recommended explicitly
- more likely to find ca c ASAP than HG-PIN
~5% of bx's get "atypical, suspicious for ca" dx
- high % of re-bx specimens (up to 85% have ca in the same or adjacent sextant site)
- more like to have ca if dx is "atypical, suspicious for ca" rather than "atypical, favor b9"
Features Arguing Against the Dx of AC:
- Atrophic cytoplasm
- merging in c b9 glands (r/o adenosis)
- corpora amylacea
- inflam
- adjacent PIN (r/o PINATYP)
In presence of inflam, must be careful to dx ca
- reactive atypia can look very severe
- inflam tends to move away from AC of prostate
- even if stains suggest ca in a small group of glands, cannot exclude adenosis which has patchy basal cell staining

Crowded glands that look basophilic at low power c papillaray infolding resembling HG-PIN. Glands appear somewhat more infiltrative than HG-PIN and are situated in bwt more typical b9 glands. All of the atypical glands are neg for HMWK. Bc there are relatively few negatively stained glands, one cannot distinguish c certainty bwt HG-PIN and infiltrating ca

Reactive cribriform gland c assoc inflammation
Pitfalls
Fused glands
(modified Gleason pattern 4):
May be under graded when present in small foci
- On the other hand, careful evaluation of multiple tissue levels may be necessary to determine whether few glands are truly fused or simply tangentially cut
Ill defined or poorly formed glands
- Ill defined glands with poorly formed glandular lumina should be graded as pattern 4
- Caution should be applied in distinguishing them from tangentially sectioned very small “well formed” (Gleason pattern 3) glands
Prostatic Duct (largte duct or endometrioid) Adenocarcinoma
Up to 1.3% of prostate ca's have tall pseudostratified columnar cells, which are classified as pure prostatic duct ac
- originally thought to be an "endometrial" tumor from remnant mullerian structures (tho proven to be prostate in origin, so don't call it endometrial/-oid!)
- usually found mixed c tumor c acinar differentiation
- should NOT call it prostatic duct carcinoma, bc also refers to prostatic duct urothelial ca
- usually found around verumontanum
- can present c obstructive sx or hematuria
- tho strongly expresses PSA, serum PSA normal
- variety of architectural patterns: papillry, solid papillary, solid nests, cribriform, PIN-like, individual glands
Micro: Endometrioid appearance c tall pseudostratified columnar cells
IHC: (+) PSA, PSAP
- neg: thrombomodulin, GATA3
- may want to stain c B-catenin, CDX-2 or villin to r/o colonic ac
Genes: TMPRSS2-ERG fusion seen less frequently than in acinar ca

Prostatic duct AC

Papillary prostatic duct AC lined by goblet cells

Cribriform prostatic duct AC

PIN-like ductal AC; note the strip of epithelium at the bottom that is from a dilated prostatic gland; most glands have flat architecture without tufting (which is seen in HG-PIN)
Neuroendocrine Differentiation in Benign and Malignant Prostate
NE cells in normal prostate histology
- small subset of cells, randomly scattered in the epithelium of prostate glands
- have variety of hormones: serotonin, chromogranin A, calcitonin, neuropeptide Y, VIP, bombesin-releasing peptide, neuron specific enolase (NSE), CD56, and several not used in clinical practice (cytochrome b561, SV2, VMAT, synaptobrevin)
- rest on the basal cell layer bwt secretory cells and protrude towards the lumen
- do not reach the lumen but have narrow apical and lateral dendritic extensions
IHC: (+) synaptophysin, chromogranin, CD56
Prostatic Adenocarcinoma c Neuroendocrine Differentiation (PCND)
PSA pos in the usual AC with scattered pos in large groups of cells that express NE markers
- most prostates have at least focal NE marker positivity since NE cells are normal constituent of prostate, though only ~1/10 prostate adenoca's have large groups of cells c NE positivity
- usually presents after tx c Androgen Deprivation Therapy (ADT) and androgen receptor inhibitors
- - NE differeniation thought to inc c dz progression and in response to ADT, and may be a mech of ADT resistance
- uncertain clinical sig, not sure whether to stain for NE diff in otherwise morphologically normal AC

[5]
Adenoca c Paneth Cell-like NE diff
- describes eosinophilic NE cells
- can be patchy or diffuse, and assoc c any grade
- uncertain sig, may not be able to grade areas with this change
Contains cells with prominent eosinophilic
cytoplasmic granules (on H&E), chromogranin +
with neurosecretory granules by EM
In some cases Paneth cell like cells lack coarse
eosinophilic granules and take on a deeply
amphophilic appearance
Paneth cell like changes can be seen as patchy
isolated cells or diffusely involving glands/nests
- well formed glands
- cords of cells with bland cytology
So at al. Hum Pathol 2014
11 cases with sparse to no Paneth cell like granules
Conventional grading would have resulted in
Gleason pattern 5 for primary or secondary pattern
10 cases entirely composed of Paneth cell like with
nests and cords like architecture
7 cases had rare granules; 3 had no granules
Diffusely chromogranin and synaptophysin + (n=8),
chromogranin + (n=2), synaptophysin + (n=1)
Ki 67 showed a very low rate of less than 5%
Keys features to recognizing these cases
nests and cords in a small focus
deeply amphophilic cytoplasm with rare Paneth
cell like eosinophilic granules in most cases
indistinct or rare visible nucleoli
+ IHC staining for NE markers
• Based on follow up from few studies, these tumors
appear to have a favorable prognosis
• Gleason grading may not be applicable
So



Paneth cell like diff

Neuroendocrine Prostate Carcinoma (NEPC) [5]
May be linked to resistance to androgen receptor inhibition, have aggressive features and dismal prognosis (~12% at 5 yrs)
- NEPC is really the general category that can be broken down into small cell carcinoma, large cell carcinoma, and carcinoid tumors, and generally does not express prostate markers
-- neuroendocrine differentiation in prostatic AC is different, and co-expresses prostate and NE markers
Carcinoid tumor
true carcinoids of the prostate are very rare, to dx:
- must not be assoc c prostatic AC (excluded by definition)
IHC : (+) NE and neg PSA markers
- must be graded like gastrointestinal ca's (with Ki67)
- if it looks like carcinoid, check for MEN syndrome
More common may be carcinoid-like ca of prostate
Small cell ca
- Rare, HG-tumor in older men where cells lacks prominent nucleoli, have nuclear molding, fragility and crush artifact (similar to small cell ca of lung); rarely have paraneoplastic syndromes assoc
- about 1/2 have hx of prostatic AC, usually c 2-year interval from dx
- usually have mets to lung; tho may be a met itself (TTF-1 is of limited use)
- prostatic small cell lacks ERG expression (usually found in prostatic AC
- tx: since it is a systemic dz that requires chemotx, try to target c-kit, Bcl2, CD56

[5]
Prostatic Small Cell Carcinoma (SCC) vs. High Grade Prostatic Carcinoma (PCA) (Epstein et al. Am J Surg Pathol 2014)

Large cell NE ca
very rare; large cells arranged in nests c peripheral pallisading vesicular nuclei, abundant cytoplasm, prominent nucleoli, and have lots of mits, necrosis,
- the cells are usually larger than those in prostatic AC
(+) CD56, CD57, chromogranin A, synaptophysin, P504S
- Ki67 >50%
- may be assoc c small cell ca and AC
- usually a hybrid c prostatic AC
- prognosis is about as poor as small cell ca (~7 mo)

[5]
Mixed NE Ca - Acinar AC
Not infrequent to have a mixed small cell and prostate AC; should have a fairly distinctive transition zone
- may not be necessary to do IHC
Prostate Ca c Overlapping features of Small cell and Acinar AC
morphologic concern for NE ca, but has cytology not typical for either small cell ca or conventional acinar
Muncinous differentiation in Benign and Malignant Prostate
B9 secretory cells of prostate have scant neutral mucin
- adenosis and sometimes atrophic glands can have acid mucin
Mucous gland metaplasia
- 1% of b9 prostates can have mucinous metaplasia
- columnar cells c pink mucin and small dark basal nuclei
IHC: (+)
neg: PSA, PSAP
Mucinous (colloid) AC
- one of the (least common) LC forms of prostate cancer; pools of extracellular mucin should occupy at least 1/4 of tumor, otherwise is called a prostate AC c focal mucinous diff
- px probably not different
- genes: may have inc change of TMPRSS2-ERG gene fusion
- DDx: mucinous AC of bladder, urethra, or colon

Mucous gland metaplasia
Mucinous (colloid) AC

Benign and Malignant Prostate Post Treatment
Antiandrogen therapy
Testosterone (T) converted to DiHydroTestosterone (DHT) by 2 5-a-reductase
- finasteride inhibits 2 5 a-reductase, thus reducing DHT and prostate volume, which can alleviate sx in some dudes
-- finasteride does not change the histology of b9 or malignant glands
Lupron is a luteinizing hormone-releasing hormone (LHRH) agonist in assoc c antiandrogen flutamide
- goal is to provide "chemical castration" by max androgen blockade
- may cause changes of prostate histology, causing sq metaplasia
- tx c LHRH agonists and flutamide can also cause atrophic neoplastic acini, pyknotic nuclei and xanthomatous cytoplasm, or may resemble inflammatory cells
Radiation
Rads as a primary tx for prostate ac has been increasing; PSA drops after tx and if rises again >2 ng/mL known as "radiotx failure"
- may do another bx or just start tx after radiotx failure
In b9 glands, radiotx causes atrophy of glands, sq metaplasia and radiation atypia
- atrophic nuclei can pile up on each other
-- usually do not see much of a stromal rxn
- best to diff b9 vs malig prostate after radiotx on low power looking at architecture
-- b9 glands separated by more stroma
- b9 glands can have bizarre nuclei occasionally in well-formed acini
- prostate ca, which usually has a bit more cytoplasm, may not appear as atrophic
-- malig glands usually infiltrative, back to back, single cell layer, lots of cytoplasm and has diffuse atypia
- can be hard to diff HG-PIN after radiotx
- HMWK, AMACR and p63 may help to diff b9 and malig
Atypia assoc c brachytherapy dec over time

Sq metaplasia and basal cell hypertrophy 2/2 antiandrogen tx
b9 prostate after radiotx

AC after radiotx (right) c b9 atrophic glands (left)
Urothelial Carcinoma
Can be seen in assoc c bladder urothelial neoplasm if there is stromal extension from bladder
Differentiating HG Prostatic AC from Urothelial Ca
If bladder ca extends to prostate, has much worse px
- tx differs significantly bwt the two
- urothelial ca much more pleomorphic and mits and sometimes c giant tumor cells
- cytoplasm of prostate AC more foamy and pale, and more often has cribriforming glands
- urothelial ca forms nests, whereas prostate ac more often has infiltrating glands
- morphology may overlap sometimes
IHC: (+) PSA / PSAP specific for prostate, though is less sens as becomes more de-differentiated, in which case prostein (P501S), PSMA, and androgen receptor can be helpful
- HMWK (+) in 90% urothelial ca and 8% prostate ac (maybe more if sq metaplasia)
- CK7/20 of limited use
Intraductal Urothelial Ca involving the Prostate
Bladder urothelial ca can involve the prostate; usually be direct extension
- these cases need better tx than the standard topical chemo or immunotx for bladder ca
- findings of intraductal urothelial ca on TURP will most likely lead to radical cystaprostatectomy
- may be difficult to dx on needle bx
IHC: (+) HMWK and p63 (~2/3)
One needle bx is difficult to dx bc is a rare finding and can very closely mimic prostate ca
- may also be no history of urothelial ca
- must differentiate histologically by findings its small infiltrating nests (vs sheets in prostsate ca)
- ~1/2 urothelial ca has necrosis (rare in prostate)
- urothelial ca has greater nuclear pleomorphism, more mits, and more stromal inflam than prostate
Tx: radical surgery
Px: urothelial ca in the prostate has a poor px

Infiltrating urothelial ca c densely eosinophilic cytoplasm

Infiltrating nests of urotherlial ca c desmoplastic stromal response and irregular borders in the infiltrating glands

Use of immunohistochemistry in distinction of urothelial carcinoma from prostate adenocarcinoma. A transurethral resected bladder tumor resembling prostatic adenocarcinoma morphologically. Tumor cells with vesicular nuclei and prominent nucleoli (A). The tumor cells are positive for p63 (B), high-molecular-weight cytokeratin (C), and GATA3 (D), supporting urothelial cell carcinoma [6]
Poorly Differentiated Prostatic Carcinoma (PCA) vs. Urothelial Carcinoma (UC) (Epstein et al. Am J Surg Pathol 2014)

Urothelial carcinoma: CK7+, PSA-, NKX3.1+, GATA3+


Mesenchymal tumors and tumor-like conditions
Stromal tumors of uncertain malignant potential (STUMPs) and stromal sarcomas
Rare; diverse histologic patterns
- mean age 58 yo; usually present c lower urinary tract obstruction, abnormal DRE, hematuria, hematospermia, rectal fullness
- grossly are tan-white and can have solid or cystic appearance c smooth walled cysts c bloody, mucinous or clear fluid; microscopic up to 15 cm
Micro: 4 patterns described: 1) hypercellular stroma c scattered atypical but degenerative appearing cells mixed c b9 prostatic glands; 2) hypercellular stroma c bland fusiform stromal cells c eosinophilic cytoplasm c b9 glands mixed; 3) leaflike hypocellular fibrous stroma covered c b9 appearing prostatic epithelium similar to phylloides tumor; 4) myxoid stroma c bland stroma cells lacking admixed cells
- can have a mix of patterns
- do not confuse c BPH
- pattern 1) is the MC (~1/2)
DDx: stromal sarcoma affects younger population (STUMP rarely progresses to sarcoma)
Leiomyoma
Difficult to dx, similar to BPH
- can be up to 12 cm
- have no mits or atypia (except degen atypia maybe)
Leiomyosarcoma
MC sarcoma in the prostate in adults
- can be up to 25 cm (mean bwt 5 and 10 cm)
- usually HG c lots of mits and necrosis; tho can be intermed grade c moderate atypia and slightly elevated mits
IHC: (+) vimentin, actin, desmin
- neg: CK ([+] in 1/4)
Px: Poor

Misc Benign and Malignant Lesions
Prostatic Cysts
Can be either a utricle cyst or a retention cyst
Utricle cyst: usually outside the prostate bwt bladder and rectum, c orifice at prostate utricle; avg 26 yo; may have abnormal genitalia or renal agensis/dysgenesis
- micro: cyst walls lack epithelial lining or made of columnar, cuboidal, transitional or squamous epithelum
Retention cyst: come from prostatic acini that are dilated c clear fluid, lined by flat prostatic glandular / transition epithelium
- term "retention cyst" should only be used if pt has sx
- 1/10 have calculi
Multilocular Cysts of the Prostate
- aka Multilocular Prostatic Cystadenoma
Large multilocular cysts bwt b;adder amd rectum, which can be attached to prostate by pedicle
- well circumscribed resembling nodular hyperplasia c multiple cysts
- micro: lined by atrophic prostatic epithelium
- IHC: may stain similar to prostatic AC
Infarcts
Up to 1/4 prostates removed for BPH have infarcts
- may enlarge prostate glands
- discrete lesions c characteristic histologic zonation
- center of infarct can have coagulative necrosis and hemorrhage; c adjacent areas having reactive epithelial nests
- can also see squamous islands c central cystic formation c cell debris
Basal cell carcinomas
Greater histologic variability than basal cell hyperplasia (at the other end of the spectrum)
- can look like basal cell carcinoma of the skin
- micro: large basaloid nests ,peripheral palisading and necrosis
- can have adenoid basal cell pattern of basal cell hyperplasia (sometimes called adenoid cystic carcinoma of the prostate)
May infiltrate into the muscle bundles of the bladder neck, surrounding fat or seminal vesicles
- carcinoma may be surrounded by basal cell hyperplasia, so be careful when trying to asses whether it is infiltrative
Features that favor BCC over Basal Cell Hyperplasia:
- adenoid cystic pattern
- large basaloid nests c necrosis
- anastomosing basaloid nests and tubules centrally lined c eosinophilic cells
- variably small/ med sized nests c irreg shapes
- extension into preprostatic fat, seminal vesicles, muscle of bladder neck
- dense stromal response
- strong diffuse Bcl-2 labeling
- Ki67 >20%
IHC: Bcl-2 labels BCC more strongly and diffusely than in BCH
Px: only a small subset is aggressive
Carcinoma c Squamous Differentiation
Pure SCC have osteolytic mets, no response to estrogen tx, no inc serum acid phosphatase
- mets to liver lung and LNs
- serum PSA not inc
- must differentiate from sq metaplasia from infarct
- Primary SCC has poor px
- micro: to dx must not have glandular differentiation, no prior hormonal tx, and lack of secondary involvement of the gland by bladder or urothelial SCC
Adenosquamous ca can occur; usually seen after dx of prostatic AC after tx
- avg survival 2 years
MC tumors to secondarily involve the prostate are urothelial ca, and colorectal AC
Prostatic infarct c reactive urothelial metaplasia and recent stromal hemorrhage

Basal cell ca

Eosinophilic metaplasia

Prostatic Urethral Lesions
Prostatic Urethral Polyps (PUPs)
PUPs usually single polyps in prostatic urethra and round the verumontanum
- present c hematuria, hematospermia, dysuria, freq
- wide age range
- may be in bladder (ectopic prostatic polyp)
- submucosa has prostate glands
Micro: surface usually papillary c broad papillae lined c urothelial cells, prostatic epithelial cells or both
- glands can be packed together or dilated
- can be seen c ca, may look like colonic villous adenoma
Px: b9
Misc Urethral Polyps
Fibroepithelial Polyp
rare, all ages
- lined by normal-looking urothelium, though can be columnar
- lacks edema and inflam
- rarely can have atypical degenerative-appearing cells
Posterior Urethral Polyp
B9 polypoid lesion arising near verumontanum
- almost exclusively in younger boys <10 yrs age
- polypoid lined c normal urothelium, no branching
Polypoid urethritis
Reactive condition in prostatic urethra
- identicial to polypoid cystitis
Prostatic Urethral Polyp (PUP)

Nephrogenic Adenoma
Usually assoc c prior surgery (3/5), calculi (1/7) or trauma (1/10) or renal transplant (<1/10)
- 1/3 are <30 yo
- designated nephrogenic metaplasia bc may be reaction to injury; 12% seen in urethra
Micro: broad histologic spectrum, including Tubular,
Cystic, Polypoid papillary, Diffuse, Flat
- urothelial surface usually replaced by flat cuboidal lined epithelium
- prolif of small solid to hollow tubules lined c low columnar to cuboidal epithelium c red cytoplasm
- vascular-like structures c attenuated epithelium +/- hobnail nuclei (structures stain as epithelial by IHC)
- rare or absent nuclear atypia (except for some degenerative atypia) and mits
- prominent nucleoli should only be focally present
- can have thyroid-like secretions
- usually have some degree of muscle involvement, and look like invading ca (esp in fibromyxoid variant)
- usually assoc c acute / chronic inflam (not really seen c ca)
IHC: (+) HMWK (1/2+, so don't exclude if neg), CK7 (cytoplasmic, not very spec), PSA/PSAP (in 1/2, usually at least focally +), AMACR coupled c neg p63 (3/5, may mistake as prostate ca), PAX2 and PAX8 (due to origin from renal tubular cells, reliable marker to distinguish from prostate ca, which is neg)
- Ki67 ~2%, p53 0% (rarely 1 %)
DDx: clear cell adenocarcinoma (has diffuse nuclear hyperchromasia, mits, and more extensive muscle invasion, Ki67 ~30%, p53 ~4%)
Features mimicking PCA
• Tubules, cords, and signet ring like tubules
• Prominent nucleoli
• Muscle involvement
• Blue tinged mucinous secretions (1/3)
• Focal PSA+ (1/3) and PSAP+ (1/2)
• HMWCK in some cases
• AMACR+
Nephrogenic adenoma invading muscles

Nephrogenic adenoma c cords of cells

Papillary nephrogenic adenoma



Nephrogenic adenoma

Nephrogenic adenoma


Nephrogenic adenoma: AE1/3+, p63+, PSA+, CAM5.2+, AMACR+, PSMA+

Nephrogenic adenoma: CK7+, PAX2+, PSMA block+

Inverted papilloma of the prostatic urethra
- rare, but can get irritated
- unclear relation to ca
- can have focal sq metaplasia or papilalry fronds
Markers for Detection and Treatment of Prostatic Ca
Epigenetic Changes in Prostate Ca
changes in DNA methylation marks and epigenetic gene slincing are the earliest changes
- new assays look for DNA seq c 5-meC
- loss of GSTP1 expression (through hypermethylation) in >9/10 prostatic ca, occurs early in developing prostate ca
ERG-ETS gene fusion
chromosomal rearrangement in >1/2 prostate ca
- chromosomal rearrangement leads to fusion of androgen-responsive promoters of the TMPRSS2 gene (21q22) to one of the three members of the ETS family (ERG, ETV1 and ETV4)
- can be detected by FISH
PI3k / mTOR pathway
- plays part in cell growth and prostate ca oncogenesis
- PTEN is negative regulator of this pathway, so loss of PTEN allow mTOR pathway activation (assoc c poor px)
References
1. Epstein. Biopsy Interpretation of the Prostate. 2015
2. Netto GJ, Cheng L. Emerging Critical Role of Molecular Testing in Diagnostic Genitourinary Pathology. Arch Path Lab Med 2012
3. Histology. library.med.utah.edu/WebPath/TUTORIAL/PROSTATE/PROSTATE.html
4. Mechanisms of Disease: high-grade prostatic intraepithelial neoplasia and other proposed preneoplastic lesions in the prostate
Rodolfo Montironi, Roberta Mazzucchelli, Antonio Lopez-Beltran, Liang Cheng and Marina Scarpelli Nature Clinical Practice Urology (2007) 4, 321-332: doi:10.1038/ncpuro0815
5. Parimi V. Neuroendocrine differentiation of prostate cancer: a review. Am J CLin Exp Urol 2014;2(4):273-285
6. Xiao X et al. Practical Applications of Immunohistochemistry in the Diagnosis of Genitourinary Tumors. Arch Pathol Lab Med. 2017; 141:1181-1194
